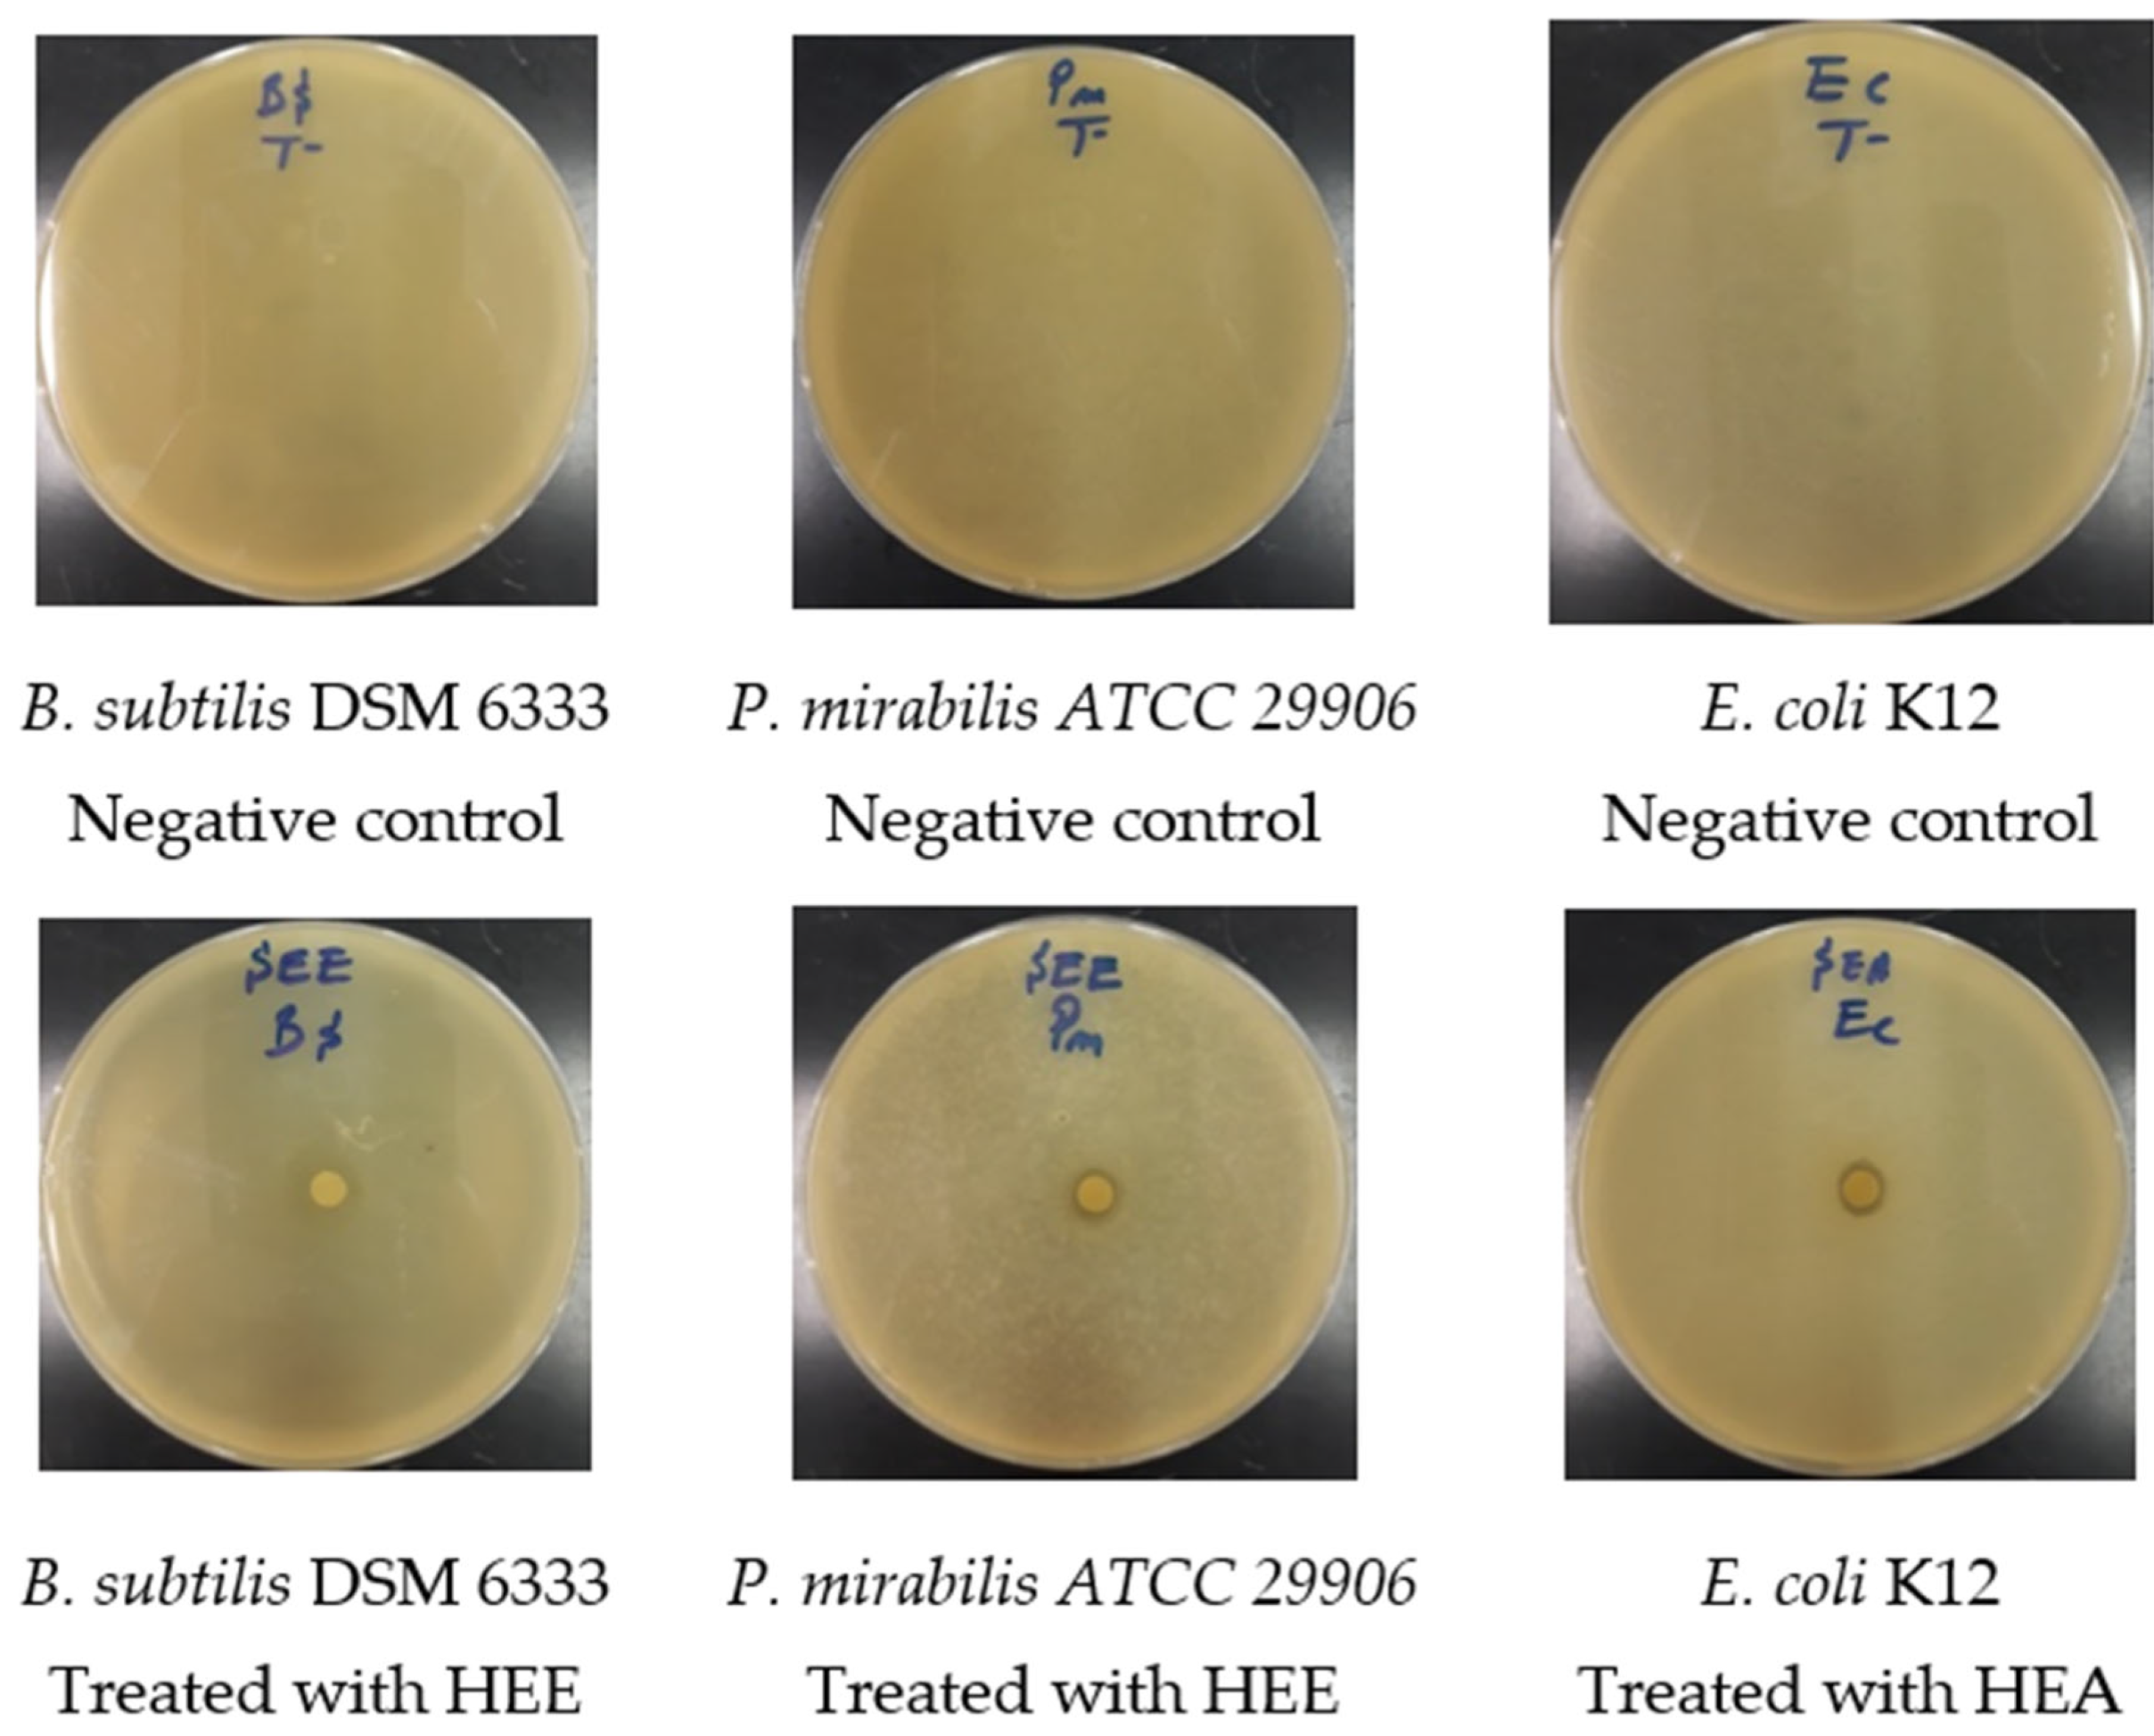
Molecules 27 04322 g006

Total Polyphenols Content, Antioxidant and Antimicrobial Activities of Leaves of Solanum elaeagnifolium Cav. from Morocco
Abstract
:1. Introduction
2. Materials and Methods
2.1. Plants Material
2.2. Preparation of Extracts by Maceration
2.3. Phytochemical Study
2.3.1. Phytochemical Screening
2.3.2. Total Polyphenols
2.3.3. Flavonoids Content
2.4. Antioxidant Activity
2.4.1. Free Radical Scavenging Activity in the DPPH
2.4.2. Reductive Power Test (FRAP)
2.4.3. Total Antioxidant Capacity (TAC)
2.5. Antimicrobial Activity of S. elaeagnifolium Hydro-Ethanolic Extract and Hydro-Acetonic Extract
2.5.1. Microbial Strains Used
2.5.2. Antimicrobial Activity
2.5.3. Inhibitory Minimum Concentration (MIC)
2.6. Statistical Analysis
3. Results and Discussion
3.1. Yield of Extracts
3.2. Phytochemical Study
3.2.1. Phytochemical Screening
3.2.2. Total Polyphenols and Flavonoids
3.3. Antioxidant Activity
3.3.1. DPPH Free Radical Scavenging Activity
3.3.2. Reductive Power Test (FRAP)
3.3.3. Total Antioxidant Capacity (TAC)
3.4. Antimicrobial Activity of S. elaeagnifolium Hydro-Ethanolic Extract and Hydro-Acetonic Extract
3.5. Relationships between Studied Parameters of S. elaeagnifolium
4. Conclusions
Author Contributions
Funding
Institutional Review Board Statement
Informed Consent Statement
Data Availability Statement
Acknowledgments
Conflicts of Interest
Sample Availability
Abbreviations
| HEE | Hydro-ethanolic extract |
| HAE | Hydro-acetonic extract |
| MIC | Minimum inhibitory concentration |
| DPPH | 2,2’-diphenyl-1 picrylhydrazyl |
| TAC | Total antioxidant capacity |
| TPC | Total polyphenol content |
| TFC | Total flavonoids content |
References
- Pan, L.; Blanco, D.; Carcache, E.J.; Kinghorn, A.D. Plant-Derived Natural Products as Leads for Drug Discovery. In Plant-Derived Natural Products; Springer: New York, NY, USA, 2009; pp. 547–567. [Google Scholar]
- Osbourn, A.; Lanzotti, V. Plant-Derived Natural Products: Synthesis, Function, and Application. Available online: https://paper/Plant-derived-natural-products-%3A-synthesis%2C-and-Osbourn-Lanzotti/a0da8f10b11ea024cc4435171e24c8077b92720e (accessed on 25 March 2022).
- Gurib-Fakim, A. Medicinal Plants: Traditions of Yesterday and Drugs of Tomorrow. Mol. Asp. Med. 2006, 27, 1–93. [Google Scholar] [CrossRef] [PubMed]
- Benkhnigue, O.; Zidane, L.; Fadli, M.; Elyacoubi, H.; Rochdi, A.; Douira, A. Etude ethnobotanique des plantes médicinales dans la région de Mechraâ Bel Ksiri (Région du Gharb du Maroc). Acta Botánica Barcinonensia 2010, 53, 191–216. [Google Scholar]
- Waksmundzka-Hajnos, M.; Sherma, J. High Performance Liquid Chromatography in Phytochemical Analysis; CRC Press: Boca Raton, FL, USA, 2010; ISBN 978-0-429-14539-1. [Google Scholar]
- Dai, J.; Mumper, R.J. Plant Phenolics: Extraction, Analysis and Their Antioxidant and Anticancer Properties. Molecules 2010, 15, 7313–7352. [Google Scholar] [CrossRef] [PubMed]
- Farag, R.S.; Daw, Z.Y.; Hewedi, F.M.; El-Baroty, G.S.A. Antimicrobial Activity of Some Egyptian Spice Essential Oils. J. Food Prot. 1989, 52, 665–667. [Google Scholar] [CrossRef] [PubMed]
- Al-Gabbiesh, A.; Kleinwaechter, M.; Selmar, D. Influencing the Contents of Secondary Metabolites in Spice and Medicinal Plants by Deliberately Applying Drought Stress during Their Cultivation. Jordan J. Biol. Sci. 2015, 8, 1–10. [Google Scholar] [CrossRef] [Green Version]
- Leong, L.P.; Shui, G. An Investigation of Antioxidant Capacity of Fruits in Singapore Markets. Food Chem. 2002, 76, 69–75. [Google Scholar] [CrossRef]
- Middleton, E.; Kandaswami, C.; Theoharides, T. The Effects of Plant Flavonoids on Mammalian Cells: Implications for Inflammation, Heart Disease, and Cancer. Pharmacol. Rev. 2000, 52, 673–751. [Google Scholar]
- Ünver, A.; Arslan, D.; Özcan, M.; Akbulut, M. Phenolic Content and Antioxidant Activity of Some Spices. World Appl. Sci. J. 2009, 6, 373–377. [Google Scholar]
- Gandhiappan, J.; Rengasamy, R. Comparative Study on Antioxidant Activity of Different Species of Solanaceae Family. Adv. Appl. Sci. Res. 2012, 7, 1538–1544. [Google Scholar]
- Brunel, S. Pest Risk Analysis for Solanum Elaeagnifolium and International Management Measures Proposed. EPPO Bull. 2011, 41, 232–242. [Google Scholar] [CrossRef]
- Houda, M.; Derbré, S.; Jedy, A.; Tlili, N.; Legault, J.; Richomme, P.; Limam, F.; Saidani-Tounsi, M. Combined Anti-AGEs and Antioxidant Activities of Different Solvent Extracts of Solanum Elaeagnifolium Cav. (Solanaceae) Fruits during Ripening and Related to Their Phytochemical Compositions. EXCLI J. 2014, 13, 1029–1042. [Google Scholar] [CrossRef] [PubMed]
- Romero, C.A.; Montoya-Inzunza, L.; Contreras, L.; Heredia, J.B.; Gutiérrez-Grijalva, E. Solanum Fruits: Phytochemicals, Bioaccessibility and Bioavailability, and Their Relationship with Their Health-Promoting Effects. Front. Nutr. 2021, 8, 790582. [Google Scholar] [CrossRef] [PubMed]
- Kaunda, J.K.; Zhang, Y.-J. The Genus Solanum: An Ethnopharmacological, Phytochemical and Biological Properties Review. Nat. Prod. Biospecting 2019, 9, 77–137. [Google Scholar] [CrossRef] [PubMed] [Green Version]
- Yarmohammadi, F.; Rahbardar, M.G.; Hosseinzadeh, H. Effect of Eggplant (Solanum Melongena) on the Metabolic Syndrome: A Review. Iran. J. Basic Med. Sci. 2021, 24, 420–427. [Google Scholar] [CrossRef]
- Njeh, F.; Feki, H.; Koubaa, I.; Hamed, N.; Mohamed, D.; Ayadi, A.; Hammami, H.; Jarraya, R. Molluscicidal Activity of Solanum Elaeagnifolium Seeds against Galba Truncatula Intermediate Host of Fasciola Hepatica: Identification of β-Solamarine. Pharm. Biol. 2015, 54, 726–731. [Google Scholar] [CrossRef] [Green Version]
- Al-hamaideh, K.; Dmour, I.; El-Elimat, T.; Afifi, F. UPLC-MS Profile and Anti-Proliferative Activity of the Berries of an Aggressive Wild-Growing Weed: Solanum Elaeagnifolium Cav. (Solanaceae). Trop. J. Nat. Prod. Res. 2020, 4, 1131–1138. [Google Scholar] [CrossRef]
- Radwan, M.; Badawy, A.; Zayed, R.; Hassanin, H.; Elsohly, M.; Ahmed, S. Cytotoxic Flavone Glycosides from Solanum Elaeagnifolium. Med. Chem. Res. 2014, 24, 1326–1330. [Google Scholar] [CrossRef]
- Hawas, U.W.; Soliman, G.M.; Abou El-Kassem, L.T.; Farrag, A.R.H.; Mahmoud, K.; León, F. A New Flavonoid C-Glycoside from Solanum Elaeagnifolium with Hepatoprotective and Curative Activities against Paracetamol-Induced Liver Injury in Mice. Z. Nat. C J. Biosci. 2013, 68, 19–28. [Google Scholar]
- Badawy, A.; Zayed, R.; Ahmed, S.; Hassanean, H. Phytochemical and Pharmacological Studies of Solanum Elaeagnifolium Growing in Egypt. J. Nat. Prod. 2013, 6, 156–167. [Google Scholar]
- Balavivekananthan, S.; Xavier, T.F.; Kumar, S.R.S.; Sabitha, R. Antibacterial Activity of Solanum Elaeagnifolium Cav. Stem and Leaf Extract against Human Pathogenic Bacteria. Res. J. Pharm. Technol. 2021, 14, 1339–1345. [Google Scholar] [CrossRef]
- Mssillou, I.; Agour, A.; Hamamouch, N.; Badiaa, L.; Derwich, E. Chemical Composition and In Vitro Antioxidant and Antimicrobial Activities of Marrubium Vulgare L. Sci. World J. 2021, 2021, 7011493. [Google Scholar] [CrossRef] [PubMed]
- Bruneton, J.; Poupon, E. Pharmacognosie, Phytochimie, Plantes Médicinales, 5th ed; Lavoisier Tec & Doc: Paris, France, 2016; ISBN 978-2-7430-2165-8. [Google Scholar]
- Li, H.-B.; Cheng, K.-W.; Wong, C.-C.; Fan, K.-W.; Chen, F.; Jiang, Y. Evaluation of Antioxidant Capacity and Total Phenolic Content of Different Fractions of Selected Microalgae. Food Chem. 2007, 102, 771–776. [Google Scholar] [CrossRef]
- Kosalec, I.; Bakmaz, M.; Pepeljnjak, S.; Vladimir-Knezevic, S. Quantitative Analysis of the Flavonoids in Raw Propolis from Northern Croatia. Acta Pharm. 2004, 54, 65–72. [Google Scholar] [PubMed]
- Ba, K.; Tine, E.; Destain, J.; Cisse, N.; Thonart, P. Comparative Study of Phenolic Compounds, Antioxidant Power of Various Senegalese Sorghum Cultivars and Amylolytic Enzymes of Their Malt. Biotechnol. Agron. Soc. Environ. 2010, 14, 131–139. [Google Scholar]
- Koncić, M.Z.; Kremer, D.; Karlović, K.; Kosalec, I. Evaluation of Antioxidant Activities and Phenolic Content of Berberis Vulgaris L. and Berberis Croatica Horvat. Food Chem. Toxicol. 2010, 48, 2176–2180. [Google Scholar] [CrossRef]
- Agour, A.; Mssillou, I.; Mechchate, H.; Es-Safi, I.; Allali, A.; El Barnossi, A.; Al Kamaly, O.; Alshawwa, S.Z.; El Moussaoui, A.; Bari, A.; et al. Brocchia Cinerea (Delile) Vis. Essential Oil Antimicrobial Activity and Crop Protection against Cowpea Weevil Callosobruchus maculatus (Fab.). Plants 2022, 11, 583. [Google Scholar] [CrossRef]
- Kara, M.; Assouguem, A.; Fadili, M.E.; Benmessaoud, S.; Alshawwa, S.Z.; Kamaly, O.A.; Saghrouchni, H.; Zerhouni, A.R.; Bahhou, J. Contribution to the Evaluation of Physicochemical Properties, Total Phenolic Content, Antioxidant Potential, and Antimicrobial Activity of Vinegar Commercialized in Morocco. Molecules 2022, 27, 770. [Google Scholar] [CrossRef]
- El Barnossi, A.; Moussaid, F.; Iraqi, H.A. Antifungal Activity of Bacillus Sp. Gn-A11-18 Isolated from Decomposing Solid Green Household Waste in Water and Soil against Candida Albicans and Aspergillus Niger. E3S Web Conf. 2020, 150, 02003. [Google Scholar] [CrossRef]
- Sarker, S.D.; Nahar, L.; Kumarasamy, Y. Microtitre Plate-Based Antibacterial Assay Incorporating Resazurin as an Indicator of Cell Growth, and Its Application in the In Vitro Antibacterial Screening of Phytochemicals. Methods 2007, 42, 321–324. [Google Scholar] [CrossRef]
- Kara, M.; Assouguem, A.; Kamaly, O.M.A.; Benmessaoud, S.; Imtara, H.; Mechchate, H.; Hano, C.; Zerhouni, A.R.; Bahhou, J. The Impact of Apple Variety and the Production Methods on the Antibacterial Activity of Vinegar Samples. Molecules 2021, 26, 5437. [Google Scholar] [CrossRef]
- Chebbac, K.; Ghneim, H.K.; El Moussaoui, A.; Bourhia, M.; El Barnossi, A.; Ouaritini, Z.B.; Salamatullah, A.M.; Alzahrani, A.; Aboul-Soud, M.A.M.; Giesy, J.P.; et al. Antioxidant and Antimicrobial Activities of Chemically-Characterized Essential Oil from Artemisia. Molecules 2022, 27, 1136. [Google Scholar] [CrossRef] [PubMed]
- Feki, H.; Koubaa, I.; Damak, M. Secondary Metabolites and Antioxidant Activity of Seed Extracts from Solanum Elaeagnifolium Cav. Mediterr. J. Chem. 2014, 2, 639–647. [Google Scholar] [CrossRef]
- Rajalakshmi, P.; Pugalenthi, M. Phytochemical Screening and In Vitro Antioxidant Activity of Lantana Camara L. and Solanum Elaeagnifolium C. Int. J. Bot. Stud. 2016, 1, 26–29. [Google Scholar]
- Hmamou, A.; Eloutassi, N.; Alshawwa, S.; Kamaly, O.; Kara, M.; Bendaoud, A.; El-Assri, E.-M.; Tlemcani, S.; Mostafa, E.K.; Lahkimi, A. Total Phenolic Content and Antioxidant and Antimicrobial Activities of Papaver Rhoeas L. Organ Extracts Growing in Taounate Region, Morocco. Molecules 2022, 27, 854. [Google Scholar] [CrossRef]
- Janovik, V.; Boligon, A.A.; Bandeira, R.V.; Linde Athayde, M. HPLC/DAD Analysis, Determination of Total Phenolic and Flavonoid Contents and Antioxidant Activity from the Leaves of Cariniana Domestica (Mart) Miers. Res. J. Phytochem. 2011, 5, 209–215. [Google Scholar] [CrossRef] [Green Version]
- Blazeković, B.; Vladimir-Knezević, S.; Brantner, A.; Stefan, M.B. Evaluation of Antioxidant Potential of Lavandula x Intermedia Emeric Ex Loisel. “Budrovka”: A Comparative Study with L. angustifolia Mill. Molecules 2010, 15, 5971–5987. [Google Scholar] [CrossRef] [Green Version]
- Effect of Organic Solvents and Water Extraction on the Phytochemical Profile and Antioxidant Activity of Clitoria Ternatea Flowers|ACS Food Science & Technology. Available online: https://pubs.acs.org/doi/abs/10.1021/acsfoodscitech.1c00168 (accessed on 12 June 2022).
- Khalil, A.; Dababneh, B.F.; Al-Gabbiesh, A.H. Antimicrobial Activity against Pathogenic Microorganisms by Extracts from Herbal Jordanian Plants. J. Food Agric. Environ. 2009, 7, 103–106. [Google Scholar]
- Sharma, P.; Tyagi, A.; Bhansali, P.; Pareek, S.; Singh, V.; Ilyas, A.; Mishra, R.; Poddar, N.K. Saponins: Extraction, Bio-Medicinal Properties and Way Forward to Anti-Viral Representatives. Food Chem. Toxicol. 2021, 150, 112075. [Google Scholar] [CrossRef]
- Moyo, B.; Masika, P.J.; Muchenje, V. Antimicrobial Activities of Moringa Oleifera Lam Leaf Extracts. Afr. J. Biotechnol. 2012, 11, 2797–2802. [Google Scholar] [CrossRef]
- Lu, M.; Li, T.; Wan, J.; Li, X.; Yuan, L.; Sun, S. Antifungal Effects of Phytocompounds on Candida Species Alone and in Combination with Fluconazole. Int. J. Antimicrob. Agents 2017, 49, 125–136. [Google Scholar] [CrossRef]
- Gutiérrez-del-Río, I.; Fernández, J.; Lombó, F.; Universitario, I.; Oncología, D.; De Asturias, P.; Instituto, I.; Sanitaria, D.I. Plant Nutraceuticals as Antimicrobial Agents in Food Preservation: Terpenoids, Polyphenols and Thiols. Int. J. Antimicrob. Agents 2018, 52, 309–315. [Google Scholar] [CrossRef] [PubMed]
- Manso, T.; Lores, M.; de Miguel, T. Antimicrobial Activity of Polyphenols and Natural Polyphenolic Extracts on Clinical Isolates. Antibiotics 2022, 11, 46. [Google Scholar] [CrossRef] [PubMed]
- Cushnie, T.P.T.; Cushnie, B.; Lamb, A.J. Alkaloids: An Overview of Their Antibacterial, Antibiotic-Enhancing and Antivirulence Activities. Int. J. Antimicrob. Agents 2014, 44, 377–386. [Google Scholar] [CrossRef] [PubMed]
- Belščak-Cvitanović, A.; Durgo, K.; Huđek, A.; Bačun-Družina, V.; Komes, D. 1—Overview of Polyphenols and Their Properties. In Polyphenols: Properties, Recovery, and Applications; Galanakis, C.M., Ed.; Woodhead Publishing: Sawston, UK, 2018; pp. 3–44. ISBN 978-0-12-813572-3. [Google Scholar]
- Del Rio, D.; Rodriguez-Mateos, A.; Spencer, J.P.E.; Tognolini, M.; Borges, G.; Crozier, A. Dietary (Poly)Phenolics in Human Health: Structures, Bioavailability, and Evidence of Protective Effects against Chronic Diseases. Antioxid. Redox Signal. 2013, 18, 1818–1892. [Google Scholar] [CrossRef] [Green Version]
- Kaurinovic, B.; Vastag, D. Flavonoids and Phenolic Acids as Potential Natural Antioxidants; IntechOpen: London, UK, 2019; ISBN 978-1-78923-920-1. [Google Scholar]
- Muniyandi, K.; George, E.; Sathyanarayanan, S.; George, B.P.; Abrahamse, H.; Thamburaj, S.; Thangaraj, P. Phenolics, Tannins, Flavonoids and Anthocyanins Contents Influenced Antioxidant and Anticancer Activities of Rubus Fruits from Western Ghats, India. Food Sci. Hum. Wellness 2019, 8, 73–81. [Google Scholar] [CrossRef]
- Plumb, G.W.; De Pascual-Teresa, S.; Santos-Buelga, C.; Cheynier, V.; Williamson, G. Antioxidant Properties of Catechins and Proanthocyanidins: Effect of Polymerisation, Galloylation and Glycosylation. Free Radic. Res. 1998, 29, 351–358. [Google Scholar] [CrossRef]
- Erika, C.; Anna, M. Antibacterial Activity of Polyphenols. Curr. Pharm. Biotechnol. 2014, 15, 380–390. [Google Scholar] [CrossRef]

| Tests | Solvent Extracts | |
|---|---|---|
| Hydro-Ethanolic Extract (HEE) | Hydro-Acetonic Extract (HAE) | |
| Tannins | + | + |
| Flavonoids | + | + |
| Alkaloids | + | + |
| Polyphenols | + | + |
| Saponins | + | − |
| Steroids | + | + |
| Extract | Polyphenols (mg EAG/g Extract) | Flavonoids (mg EQ/g Extract) |
|---|---|---|
| Hydro-ethanolic | 2.54 ± 0.4 a | 0.012 ± 0.001 a |
| Hydro-acetonic | 1.58 ± 0.03 b | 0.067 ± 0.001 b |
| Hydro-Ethanolic | Hydro-Acetonic | BHT | |
|---|---|---|---|
| DPPH-IC50 | 0.0807 ± 0.0039 mg/mL b | 0.198 ± 0.0196 mg/mL c | 0.122 ± 0.0210 μg/mL a |
| FRAP-EC50 | 0.0825 ± 0.0051 mg/mL b | 0.1157 ± 0.0400 mg/mL c | 0.362 ± 0.0100 µg/mL a |
| S. aureus ATCC 6633 | E. coli K12 | B. subtilis DSM 6333 | P. mirabilis ATCC 29906 | C. albicans ATCC 10231 | |
|---|---|---|---|---|---|
| S. elaeagnifolium HEE (mg/mL) | 7.5 ± 0.00 a | 7.5 ± 0.00 a | 15 ± 0.00 b | 15 ± 0.00 b | - |
| S. elaeagnifolium HAE (mg/mL) | 3.75 ± 0.00 a | 3.75 ± 0.00 a | 7.5 ± 0.00 b | 7.5 ± 0.00 b | - |
| Polyphenols | Flavonoids | DPPH | FRAP | TAC | DIZ (S.a) | DIZ (E. coli) | DIZ (B.s) | DIZ (P.m) | CMI (S.a) | CMI (E. coli) | CMI (B.s) | CMI (P.m) | |
|---|---|---|---|---|---|---|---|---|---|---|---|---|---|
| Polyphenols | 1.000 | ||||||||||||
| Flavonoids | −0.999 | 1.000 | |||||||||||
| DPPH | −0.995 | 0.994 | 1.000 | ||||||||||
| FRAP | 0.992 | −0.997 | −0.991 | 1.000 | |||||||||
| TAC | 0.943 | −0.946 | −0.924 | 0.932 | 1.000 | ||||||||
| DIZ (S.a) | −0.646 | 0.646 | 0.613 | −0.645 | −0.513 | 1.000 | |||||||
| DIZ (E. coli) | 0.673 | −0.650 | −0.652 | 0.600 | 0.759 | −0.429 | 1.000 | ||||||
| DIZ (B.s) | 0.960 | −0.968 | −0.966 | 0.977 | 0.906 | −0.491 | 0.491 | 1.000 | |||||
| DIZ (P.m) | 0.526 | −0.551 | −0.554 | 0.597 | 0.429 | −0.071 | −0.213 | 0.733 | 1.000 | ||||
| MIC (S.a) | 0.998 | −0.999 | −0.993 | 0.997 | 0.947 | −0.655 | 0.655 | 0.965 | 0.542 | 1.000 | |||
| MIC (E. coli) | 0.998 | −0.999 | −0.993 | 0.997 | 0.947 | −0.655 | 0.655 | 0.965 | 0.542 | 1.000 | 1.000 | ||
| MIC (B.s) | 0.998 | −0.999 | −0.993 | 0.997 | 0.947 | −0.655 | 0.655 | 0.965 | 0.542 | 1.000 | 1.000 | 1.000 | |
| MIC (P.m) | 0.998 | −0.999 | −0.993 | 0.997 | 0.947 | −0.655 | 0.655 | 0.965 | 0.542 | 1.000 | 1.000 | 1.000 | 1.000 |
Publisher’s Note: MDPI stays neutral with regard to jurisdictional claims in published maps and institutional affiliations. |
© 2022 by the authors. Licensee MDPI, Basel, Switzerland. This article is an open access article distributed under the terms and conditions of the Creative Commons Attribution (CC BY) license (https://creativecommons.org/licenses/by/4.0/).
Share and Cite
Bouslamti, M.; El Barnossi, A.; Kara, M.; Alotaibi, B.S.; Al Kamaly, O.; Assouguem, A.; Lyoussi, B.; Benjelloun, A.S. Total Polyphenols Content, Antioxidant and Antimicrobial Activities of Leaves of Solanum elaeagnifolium Cav. from Morocco. Molecules 2022, 27, 4322. https://doi.org/10.3390/molecules27134322
Bouslamti M, El Barnossi A, Kara M, Alotaibi BS, Al Kamaly O, Assouguem A, Lyoussi B, Benjelloun AS. Total Polyphenols Content, Antioxidant and Antimicrobial Activities of Leaves of Solanum elaeagnifolium Cav. from Morocco. Molecules. 2022; 27(13):4322. https://doi.org/10.3390/molecules27134322
Chicago/Turabian StyleBouslamti, Mohammed, Azeddine El Barnossi, Mohammed Kara, Badriyah S. Alotaibi, Omkulthom Al Kamaly, Amine Assouguem, Badiaa Lyoussi, and Ahmed Samir Benjelloun. 2022. "Total Polyphenols Content, Antioxidant and Antimicrobial Activities of Leaves of Solanum elaeagnifolium Cav. from Morocco" Molecules 27, no. 13: 4322. https://doi.org/10.3390/molecules27134322
APA StyleBouslamti, M., El Barnossi, A., Kara, M., Alotaibi, B. S., Al Kamaly, O., Assouguem, A., Lyoussi, B., & Benjelloun, A. S. (2022). Total Polyphenols Content, Antioxidant and Antimicrobial Activities of Leaves of Solanum elaeagnifolium Cav. from Morocco. Molecules, 27(13), 4322. https://doi.org/10.3390/molecules27134322

